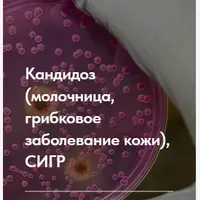
Лечебный протокол: Кандидоз, молочница, грибковые заболевания кожи

Кишечник: запор, диарея, СИБР, СРК
Постоянное вздутие, дискомфорт после еды и непредсказуемая работа кишечника часто связаны не с внешними факторами, а с конкретными нарушениями моторики и микрофлоры, которые можно скорректировать. Серия лекций помогает разобраться в причинах сбоев работы ЖКТ, чтобы уйти от бесконечного приема слабительных и остановить цикл «вздутие — диета — рецидив».
Внутри разбираются механизмы развития запоров и диареи, стратегии питания при СИБР (включая протоколы Low FODMAP и работу с гистамином), а также нюансы подбора нутрицевтиков и ферментов. Вы научитесь различать виды функциональных нарушений, поймете, как вегетативная нервная система управляет моторикой и когда действительно необходима помощь врача. Материал ориентирован на людей с хроническими расстройствами стула, синдромом раздраженного кишечника (СРК) или подтвержденным СИБР, которые хотят составить индивидуальный план поддержки ЖКТ.
Другие материалы автора
Хелик в балансе
Венера ХабироваРабота со стрессом: Вегетатика и надпочечники
Венера Хабирова Можно купить
Можно купитьПолюби свою кислотность
Венера ХабироваКлуб Gastrosmile
Венера Хабирова Можно купить
Можно купитьСиндром избыточного бактериального роста
Венера Хабирова Можно купить
Можно купитьБеги желчь, беги + Лекция Камни в желчном
Венера ХабироваКогда диеты не работают: подбери питание под себя
Венера Хабирова Можно купить
Можно купитьУдаленный желчный пузырь
Венера Хабирова Можно купить
Можно купитьПомощь пищеварению: подбери себе ферменты и горечи
Венера Хабирова Можно купить
Можно купитьВообще всё про Рефлюкс: кисло/горько во рту, изжога и ГЭРБ
Венера Хабирова Можно купить
Можно купитьЖелезо – ты как? или как восполнить дефицит при проблемах ЖКТ
Венера ХабироваАвтор обладает талантом видеть пути решения сложных проблем. Материал излагается точно, четко и понятно. Индивидуальный подход к вопросам, отсутствие шаблонных схем и решений.
Всё отлично. Точка
Ещё интересные курсы
Похудеть навсегда
Анна и Олег НетребаКакая у меня кислотность
Венера ХабироваПоказатели метаболического здоровья
Елена Иванова Можно купить
Можно купитьЛечебный протокол: Кандидоз, молочница, грибковые заболевания кожи
Елена Ержанова Можно купить
Можно купить5 шагов к здоровому пищеварению
Ольга Помойнецкая Можно купить
Можно купитьГайд по железодефициту + Коррекция питания по Дошам + Сезонная Персонализация питания
Валерия Гезер Предзаказ
ПредзаказПищевая аллергия
Владимир Чикунов Предзаказ
ПредзаказКак помочь сложному подопечному с холангитом (разбор кейса)
Кристина Трофимова Можно купить
Можно купитьЧек-лист: Гипертония
Альфия Понамарева Предзаказ
ПредзаказТрендовые десерты в ПП варианте
Вера Ру Можно купить
Можно купитьОРВИ. Пособие по нутрицевтической поддержке
Ирина Зезулева Можно купить
Можно купить